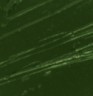

г.Москва
info@uveto.ru
Россия
|
Новости: |
| АКЦИЯ "Вас ждёт подарок!"
Работа Магазина в дни празднования Нового Года Исполнение заказов в дни самоизоляции. Портал поставщиков |
Каталог:

Артикул магазина: F02651
| Характеристики: | |
| Название | Краска масляная XL |
| Фирма | "PEBEO" |
| Кол-во (в упаковке) | 1 шт |
| Объем | 80 мл |
| Артикул производителя | 9800 |
| Описание | Современная тонко тертая масляная краска. Имеет глубокий оттенок и пастозную консистенцию. Высыхает в течение 3-6 дней. Высокая термо и светостойкость. Поверхности: холст, правильно подготовленные картон, дерево, ДВП или ДСП. Подходят для любых техник, для лессировок и для пастозной живописи. Все краски смешиваются друг с другом. Покрытие лаком через 6-9 месяцев. Разбавление: разбавители, масла или медиумы в зависимости от искомого результата. Очистка инструментов: нефтяное масло. |
| Страна | Франция |
Внимание, описание товара на сайте носит информационный характер и не является публичной офертой.
Оно может отличаться от описания, представленного в технической документации производителя.
Во избежание недоразумений при покупке товаров уточняйте информацию у менеджеров. | |
|
| г. Москва, Россия +7-499-704-2222 info@uveto.ru |
|